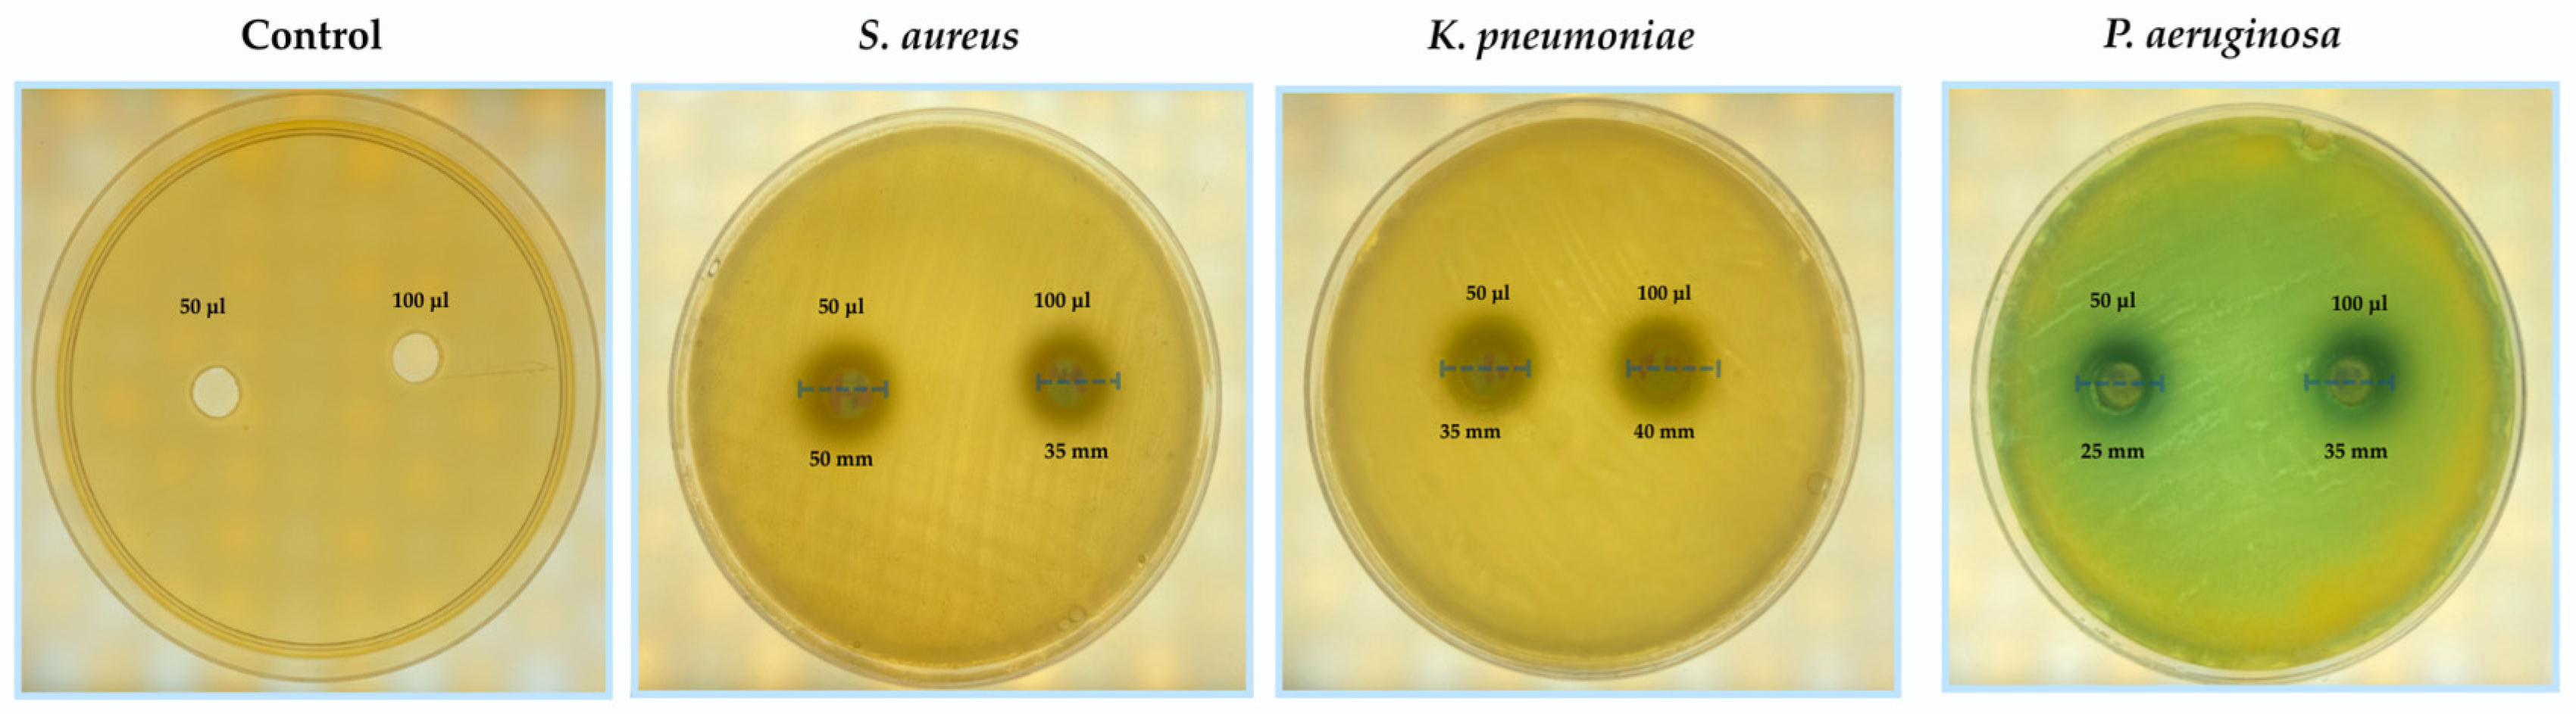
Applmicrobiol 05 00122 g004 Applmicrobiol 05 00122 g004

Thermostable Collagenase Derived from Streptomyces scabies Demonstrates Selective Antibacterial Activity Against Infections in Diabetic Foot Ulcers
Abstract
1. Introduction
2. Materials and Methods
2.1. Microorganisms
2.2. Primary Screening for Collagenolytic Activity
2.3. Collagenase Assay
2.4. Optimization of Collagenase Production
2.5. Enzyme Purification
2.6. Molecular Weight Determination
2.7. Antibacterial Activity and Statistical Analysis
3. Results
3.1. Morphological and Molecular Identification
3.2. Optimization of Collagenase Production
3.3. Biochemical Properties of Collagenase
3.4. Enzyme Purification and Molecular Weight
3.5. Antibacterial Activity
4. Discussion
5. Conclusions
Author Contributions
Funding
Data Availability Statement
Acknowledgments
Conflicts of Interest
Abbreviations
| DFUs | Diabetic foot ulcers |
| SDS-PAGE | Sodium dodecyl sulfate–polyacrylamide gel electrophoresis |
| IWGDF | The International Working Group on the Diabetic Foot |
| MRSA | Methicillin-resistant Staphylococcus aureus |
| ESBL | Extended-spectrum β-lactamase |
| SD | Standard deviation |
| MSC | Mesenchymal stem cell |
| EDTA | Ethylenediaminetetraacetic acid |
| NCIMB | The National Collection of Industrial, Marine and Food Bacteria |
References
- International Working Group on the Diabetic Foot (IWGDF). IWGDF Guidelines on the Prevention and Management of Diabetic Foot Disease; IWGDF: Maastricht, The Netherlands, 2019. [Google Scholar]
- Shaheen, M.M.A.; Al Dahab, S.; Abu Fada, M.; Idieis, R. Isolation and characterization of bacteria from diabetic foot ulcer: Amputation, antibiotic resistance and mortality rate. Int. J. Diabetes Dev. Ctries. 2022, 42, 529–537. [Google Scholar] [CrossRef]
- Theocharis, A.D.; Skandalis, S.S.; Gialeli, C.; Karamanos, N.K. Extracellular matrix structure. Adv. Drug Deliv. Rev. 2016, 97, 4–27. [Google Scholar] [CrossRef]
- Amadeh, A.; Mohebbi, N.; Amadeh, Z.; Jamshidbeigi, A. Comparative efficacy of autolytic and collagenase-based enzymatic debridement in chronic wound healing: A comprehensive systematic review. Int. Wound J. 2025, 22, e70177. [Google Scholar] [CrossRef]
- Pillai, N.S.; Khan, S.A.; Mehrotra, N.; Jadhav, K. A comprehensive review on the role of collagen in health and disease. Biosci. Biotechnol. Res. Asia 2024, 21, 1329–1347. [Google Scholar] [CrossRef]
- Huang, Y.; Kyriakides, T.R. The role of extracellular matrix in the pathophysiology of diabetic wounds. Matrix Biol. Plus 2020, 6–7, 100037. [Google Scholar] [CrossRef] [PubMed]
- Sinclair, R.D.; Ryan, T.J. Proteolytic enzymes in wound healing: The role of enzymatic debridement. Australas. J. Dermatol. 1994, 35, 35–41. [Google Scholar] [CrossRef]
- Alipour, H.; Raz, A.; Zakeri, S.; Dinparast Djadid, N. Therapeutic applications of collagenase (metalloproteases): A review. Asian Pac. J. Trop. Biomed. 2016, 6, 975–981. [Google Scholar] [CrossRef]
- Gross, J.; Lapiere, C.M. Collagenolytic activity in amphibian tissues: A tissue culture assay. Biochim. Biophys. Acta 1961, 51, 39–49. [Google Scholar] [CrossRef]
- Vachher, M.; Sen, A.; Kapila, R.; Nigam, A. Microbial therapeutic enzymes: A promising area of biopharmaceuticals. Curr. Res. Biotechnol. 2021, 3, 195–208. [Google Scholar] [CrossRef]
- Moya-Salazar, J.; Chamana, J.M.; Porras-Rivera, D.; Goicochea-Palomino, E.A.; Salazar, C.R.; Contreras-Pulache, H. Increase in antibiotic resistance in diabetic foot infections among Peruvian patients: A single-center cross-sectional study. Front. Endocrinol. 2023, 14, 1159847. [Google Scholar] [CrossRef]
- Caruso, P.; Maiorino, M.I.; Macera, M.; Signoriello, G.; Castellano, L.; Scappaticcio, L.; Longo, M.; Gicchino, M.; Campitiello, F.; Bellastella, G.; et al. Antibiotic resistance in diabetic foot infection: How it changed with COVID-19 pandemic in a tertiary care center. Diabetes Res. Clin. Pract. 2021, 175, 108815. [Google Scholar] [CrossRef] [PubMed]
- Chakraborty, R.; Chandra, A.L. Purification and characterization of a streptomycete collagenase. J. Appl. Bacteriol. 1986, 61, 331–337. [Google Scholar] [CrossRef]
- El-Sayed, S.T. Extracellular Collagenase Produced by Streptomyces Species: Optimum Culture Conditions. [Internet]. Available online: https://www.researchgate.net/publication/332268552 (accessed on 20 September 2025).
- Sharma, N.; Ahlawat, Y.K.; Stalin, N.; Mehmood, S.; Morya, S.; Malik, A.; Nellore, J.; Bhanot, D. Microbial enzymes in industrial biotechnology: Sources, production, and significant applications of lipases. J. Ind. Microbiol. Biotechnol. 2025, 52, 201–223. [Google Scholar] [CrossRef]
- Hisano, T.; Abe, S.; Wakashiro, M.; Kimura, A.; Murata, K. Isolation and properties of a collagenase with caseinolytic activity from a Pseudomonas sp. J. Ferment. Bioeng. 1989, 68, 399–403. [Google Scholar] [CrossRef]
- Endo, A.; Murakawa, S.; Sfflmizu, H.; Shiraishi, Y. Purification and properties of collagenase from a Streptomyces species. J. Biochem. 1987, 102, 941–949. [Google Scholar] [CrossRef]
- Pin, Y.A.; Takahashi, T. An improved colorimetric determination of amino acids with the use of ninhydrin. Anal. Biochem. 1966, 14, 71–77. [Google Scholar] [CrossRef]
- Tran, L.H.; Nagano, H. Isolation and characteristics of Bacillus subtilis CN2 and its collagenase production. J. Food Sci. 2002, 67, 1184–1188. [Google Scholar] [CrossRef]
- Laemmli, U.K.; Favre, M. Maturation of the head of bacteriophage T4. I. DNA packaging events. J. Mol. Biol. 1973, 80, 575–599. [Google Scholar] [CrossRef]
- Zhang, K.; Han, Y. Thermostable bacterial collagenolytic proteases: A review. J. Microbiol. Biotechnol. 2024, 34, 1385–1394. [Google Scholar] [CrossRef]
- Petrova, D.H.; Shishkov, S.A.; Vlahov, S.S. Novel thermostable serine collagenase from Thermoactinomyces sp. 21E: Purification and some properties. J. Basic Microbiol. 2006, 46, 275–285. [Google Scholar] [CrossRef] [PubMed]
- Petrova, D.; Vlahov, S.; Dalev, P. Purification and characterization of a thermostable alkaline collagenase from Thermoactinomyces sp. E-21 strain. Biotechnol. Biotechnol. Equip. 2001, 15, 31–38. [Google Scholar] [CrossRef]
- Abood, A.; Salman, A.M.M.; Abdelfattah, A.M.; El-Hakim, A.E.; Abdel-Aty, A.M.; Hashem, A.M. Purification and characterization of a new thermophilic collagenase from Nocardiopsis dassonvillei NRC2aza and its application in wound healing. Int. J. Biol. Macromol. 2018, 116, 801–810. [Google Scholar] [CrossRef] [PubMed]
- Baehaki, A.; Sukarno, S.; Syah, D.; Setyahadi, S.; Suhartono, M.T. Production and characterization of collagenolytic protease from Bacillus licheniformis F11.4 originated from Indonesia. Asian J. Chem. 2014, 26, 2861–2864. [Google Scholar] [CrossRef]
- Baehaki, A. Purification and characterization of collagenase from Bacillus licheniformis F11.4. Afr. J. Microbiol. Res. 2012, 6, 2392–2398. [Google Scholar] [CrossRef]
- Natsir, H.; Dali, S. Production and characterization of collagenase from Bacillus sp. 6-2 isolated from fish liquid waste. J. Pure Appl. Microbiol. 2019, 12, 701–708. [Google Scholar]
- Ferreira, C.M.O.; Correia, P.C.; Brandão-Costa, R.M.P.; Albuquerque, W.W.C.; Lin Liu, T.P.S.; Campos-Takaki, G.M.; Porto, A.L.F. Collagenase produced from Aspergillus sp. (UCP 1276) using chicken feather industrial residue. Biomed. Chromatogr. 2017, 31, e3852. [Google Scholar] [CrossRef] [PubMed]
- Kate, S.; Pethe, A. Study of collagenase production by Penicillium sp. isolated from deteriorated leather sample. J. Adv. Sci. Res. 2022, 13, 227–234. [Google Scholar]
- Patry, J.; Blanchette, V. Enzymatic debridement with collagenase in wounds and ulcers: A systematic review and meta-analysis. Int. Wound J. 2017, 14, 1055–1065. [Google Scholar] [CrossRef]
- Ning, P.; Liu, Y.; Kang, J.; Cao, H.; Zhang, J. Comparison of healing effectiveness of different debridement approaches for diabetic foot ulcers: A network meta-analysis of randomized controlled trials. Front. Public Health 2023, 11, 1213370. [Google Scholar] [CrossRef]
- Brzyska, A.; Mozga, K.; Karabin, A.; Bojarska, M.; Domańska, N. Healing diabetic foot ulcers: A comparative review of debridement approaches. Qual. Sport 2024, 21, 44262. [Google Scholar] [CrossRef]
- Tallis, A.; Motley, T.A.; Wunderlich, R.P.; Dickerson, J.E.; Waycaster, C.; Slade, H.B. Clinical and economic assessment of diabetic foot ulcer debridement with collagenase: Results of a randomized controlled study. Clin. Ther. 2013, 35, 1805–1820. [Google Scholar] [CrossRef]
- Miller, J.D.; Carter, E.; Hatch, D.C.; Zhubrak, M.; Giovinco, N.A.; Armstrong, D.G. Use of collagenase ointment in conjunction with negative pressure wound therapy in the care of diabetic wounds: A case series of six patients. Diabet. Foot Ankle 2015, 6, 26839. [Google Scholar] [CrossRef] [PubMed]
- Rautskis, V.P.; Khimich, S.D. Role of antimicrobial activity of collagenase-based ointment in the treatment of infected wounds in an experiment. Rep. Vinnytsia Natl. Med. Univ. 2024, 28, 383–388. [Google Scholar] [CrossRef]
- Alhayek, A.; Khan, E.S.; Schönauer, E.; Däinghaus, T.; Shafiei, R.; Voos, K.; Han, M.K.; Ducho, C.; Posselt, G.; Wessler, S.; et al. Inhibition of collagenase Q1 of Bacillus cereus as a novel antivirulence strategy for the treatment of skin-wound infections. Adv. Ther. 2022, 5, 2200065. [Google Scholar] [CrossRef] [PubMed]
- Waycaster, C.; Carter, M.J.; Gilligan, A.M.; Mearns, E.S.; Fife, C.E.; Milne, C.T. Comparative cost and clinical effectiveness of clostridial collagenase ointment for chronic dermal ulcers. J. Comp. Eff. Res. 2018, 7, 149–165. [Google Scholar] [CrossRef]
- Buta, M.R.; Annand, D.; Findeisen, S.; Hickey, S.A.; Sheridan, R.L.; Friedstat, J.S.; Schulz, J.T.; Bojovic, B.; Bittner, E.A.; Goverman, J. Pain management during bromelain-based enzymatic debridement (NexoBrid®) in a USA adult burn center. Eur. Burn J. 2024, 5, 1–11. [Google Scholar] [CrossRef]
- Galperin, R.C.; Lange, D.L.; Ramsay, S.J.; Shi, L.; Weedon, K.A.; Hudson, N.M.; Dickerson, J.E.; Cargill, D.I.; Slade, H.B. Anti-inflammatory effects of clostridial collagenase result from in vitro and clinical studies. J. Am. Podiatr. Med. Assoc. 2015, 105, 509–519. [Google Scholar] [CrossRef]
- Fahie, M.A.; Shettko, D. Evidence-based wound management: A systematic review of therapeutic agents to enhance granulation and epithelialization. Vet. Clin. N. Am. Small Anim. Pract. 2007, 37, 559–577. [Google Scholar] [CrossRef] [PubMed]
- Syed, F.; Thomas, A.N.; Singh, S.; Kolluru, V.; Hart, S.G.E.; Bayat, A. In vitro study of novel collagenase (Xiaflex®) on Dupuytren’s disease fibroblasts displays unique drug related properties. PLoS ONE 2012, 7, e31430. [Google Scholar] [CrossRef]
- Banerjee, P.; Das, A.; Singh, K.; Khanna, S.; Sen, C.K.; Roy, S. Collagenase-based wound debridement agent induces extracellular matrix supporting phenotype in macrophages. Sci. Rep. 2024, 14, 53424. [Google Scholar] [CrossRef]
- Shingleton, W.D. Collagenase: A key enzyme in collagen turnover. Biochem. Cell Biol. 1996, 74, 759–775. [Google Scholar] [CrossRef] [PubMed]
- Planus, E.; Galiacy, S.; Matthay, M.; Laurent, V.; Gavrilovic, J.; Murphy, G.; Clérici, C.; Isabey, D.; Lafuma, C.; d’Ortho, M.P. Role of collagenase in mediating in vitro alveolar epithelial wound repair. J. Cell Sci. 1999, 112, 243–252. [Google Scholar] [CrossRef]
- Kumar, L.V.; Jeyashakila, R.; Dhanabalan, V.; Manivannan, M. In vitro bioaccessibility and antioxidant properties of unicorn leatherjacket fish (Aluterus monoceros) skin collagen peptides prepared using crude collagenase enzyme isolated from fish fins. Braz. J. Dev. 2024, 10, e70488. [Google Scholar] [CrossRef]
- Quintero Sierra, L.A.; Biswas, R.; Busato, A.; Conti, A.; Ossanna, R.; Conti, G.; Zingaretti, N.; Caputo, M.; Cuppari, C.; Parodi, P.C.; et al. In vitro study of a novel Vibrio alginolyticus-based collagenase for future medical application. Cells 2023, 12, 2025. [Google Scholar] [CrossRef]
- Jorgensen, A.B.; Jonsson, I.; Friis-Hansen, L.; Brandstrup, B. Collagenase-producing bacteria are common in anastomotic leakage after colorectal surgery: A systematic review. Int. J. Colorectal Dis. 2023, 38, 140. [Google Scholar] [CrossRef]
- Krepel, C.J.; Gohr, C.M.; Edmiston, C.E., Jr.; Farmer, S.G. Anaerobic pathogenesis: Collagenase production by Peptostreptococcus and its relationship to site of infection. J. Infect. Dis. 1991, 164, 54–60. [Google Scholar] [CrossRef]
- Huett, E.; Bartley, W.; Morris, D.; Reasbeck, D.; McKitrick-Bandy, B.; Yates, C. Collagenase for wound debridement in the neonatal intensive care unit: A retrospective case series. Pediatr. Dermatol. 2017, 34, 277–281. [Google Scholar] [CrossRef]
- Yadav, P.S.; Singh, M.; Vinayagam, R.; Shukla, P. Therapies and delivery systems for diabetic wound care: Current insights and future directions. Front. Pharmacol. 2025, 16, 1628252. [Google Scholar] [CrossRef]
- Zhang, Y.Z.; Ran, L.Y.; Li, C.Y.; Chen, X.L. Diversity, structures, and collagen-degrading mechanisms of bacterial collagenolytic proteases. Appl. Environ. Microbiol. 2015, 81, 6098–6107. [Google Scholar] [CrossRef] [PubMed]
- Jones, E.M.; Cochrane, C.A.; Percival, S.L. The effect of pH on the extracellular matrix and biofilms. Adv. Wound Care 2015, 4, 431–439. [Google Scholar] [CrossRef] [PubMed]

| Category | Condition | Mean | SD | Relative Activity (%) |
|---|---|---|---|---|
| Temperature (°C) | 5 | 0.089 | 0.02 | 20.9 |
| 20 | 0.425 | 0.001 | 100 | |
| 37 | 0.265 | 0.002 | 62.3 | |
| 60 | 0.22 | 0.001 | 51.7 | |
| pH | 3 | 0.195 | 0.003 | 85.90 |
| 5 | 0.227 | 0.02 | 100 | |
| 7 | 0.055 | 0.002 | 24.22 | |
| 9 | 0.221 | 0.04 | 97.3 | |
| Substrate conc. (M) | 0.15 mL | 0.051 | 0.02 | 85 |
| 0.25 mL | 0.048 | 0.02 | 80 | |
| 0.35 mL | 0.06 | 0.02 | 100 | |
| 0.45 mL | 0.042 | 0.015 | 70 | |
| Enzyme conc. (mg/mL) | 0.05 mL | 0.474 | 0.022 | 99.7 |
| 0.06 mL | 0.473 | 0.021 | 99.5 | |
| 0.07 mL | 0.471 | 0.02 | 99.1 | |
| 0.08 mL | 0.475 | 0.02 | 100 | |
| Effect of Heavy Metals and Chemicals | Zn++ | 0.073 | 0.02 | 25.3 |
| Fe++ | 0.288 | 0.001 | 100 | |
| Hg++ | 0.139 | 0.001 | 48.2 | |
| EDTA | 0.048 | 0.003 | 16.6 |
| Bacterial Strain | Collagenase (50 µL) | Collagenase (100 µL) | p-Value | Significance |
|---|---|---|---|---|
| S. aureus | 50 ± 1.0 | 35 ± 1.5 | 0.001 | Significant |
| K. pneumoniae | 35 ± 0.5 | 40 ± 1.0 | 0.07 | NS |
| P. aeruginosa | 35 ± 0.8 | 25 ± 1.0 | 0.003 | Significant |
Disclaimer/Publisher’s Note: The statements, opinions and data contained in all publications are solely those of the individual author(s) and contributor(s) and not of MDPI and/or the editor(s). MDPI and/or the editor(s) disclaim responsibility for any injury to people or property resulting from any ideas, methods, instructions or products referred to in the content. |
© 2025 by the authors. Licensee MDPI, Basel, Switzerland. This article is an open access article distributed under the terms and conditions of the Creative Commons Attribution (CC BY) license (https://creativecommons.org/licenses/by/4.0/).
Share and Cite
Al-Kattan, M.; Baghdadi, A.; Sahloli, A. Thermostable Collagenase Derived from Streptomyces scabies Demonstrates Selective Antibacterial Activity Against Infections in Diabetic Foot Ulcers. Appl. Microbiol. 2025, 5, 122. https://doi.org/10.3390/applmicrobiol5040122
Al-Kattan M, Baghdadi A, Sahloli A. Thermostable Collagenase Derived from Streptomyces scabies Demonstrates Selective Antibacterial Activity Against Infections in Diabetic Foot Ulcers. Applied Microbiology. 2025; 5(4):122. https://doi.org/10.3390/applmicrobiol5040122
Chicago/Turabian StyleAl-Kattan, Manal, Afra Baghdadi, and Afnan Sahloli. 2025. "Thermostable Collagenase Derived from Streptomyces scabies Demonstrates Selective Antibacterial Activity Against Infections in Diabetic Foot Ulcers" Applied Microbiology 5, no. 4: 122. https://doi.org/10.3390/applmicrobiol5040122
APA StyleAl-Kattan, M., Baghdadi, A., & Sahloli, A. (2025). Thermostable Collagenase Derived from Streptomyces scabies Demonstrates Selective Antibacterial Activity Against Infections in Diabetic Foot Ulcers. Applied Microbiology, 5(4), 122. https://doi.org/10.3390/applmicrobiol5040122

